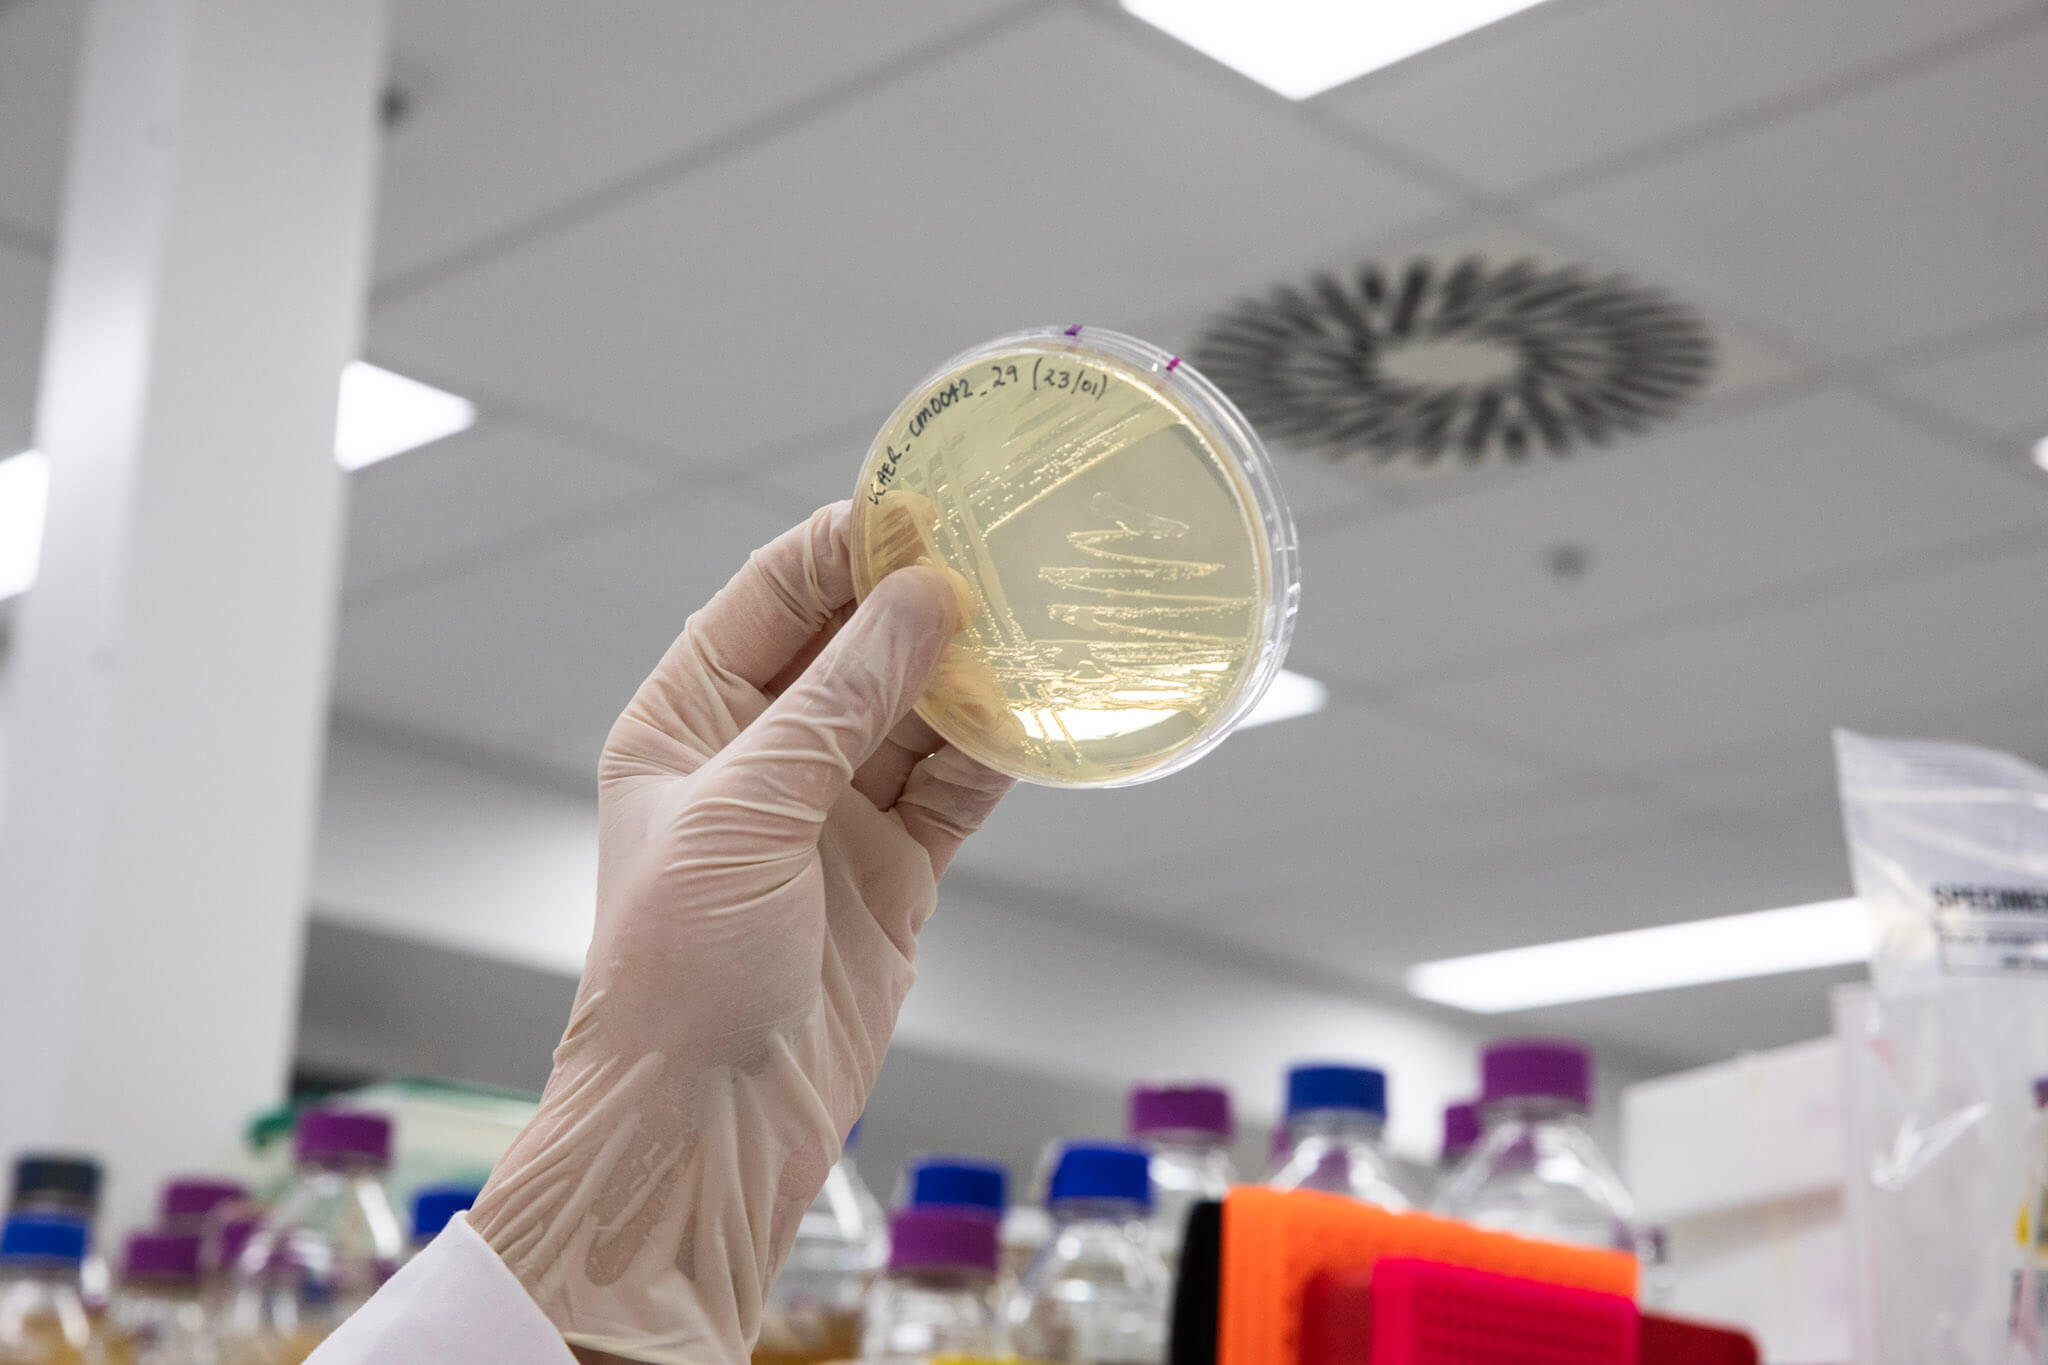
Westmead Research

DOOLEYS is so honoured to partner with The Westmead Institute for Medical Research and be able to support and promote the amazing work they do, for not only Western Sydney, but on a global scale.
DOOLEYS is proud to support their Phage Therapies Project, a breakthrough cure for superbugs that is already saving lives and looks forward to watching all their progress in this field.
Want to know more? Find out about the world class research being undertaken right now at the heart of Western Sydney and how you can get involved - https://www.westmeadinstitute.org.au/
About Westmead Institute for Medical Research:
WIMR exists to turn medical research discoveries into breakthroughs that save lives and deliver hope.
The world-leading researchers at WIMR work collaboratively. They are passionate, dedicated and brilliant, with a personal connection that is second to none. WIMR researchers are driven and thrive on solving medical challenges. They champion life-changing medical research through personal connection. It's the brilliance, warmth and passion of our people that makes WIMR outstanding.
WIMR is making breakthroughs in medical research and applying these discoveries to some of the world’s most serious diseases. These include illnesses like HIV; diabetes; cancers; heart, kidney and liver issues and deadly viruses.